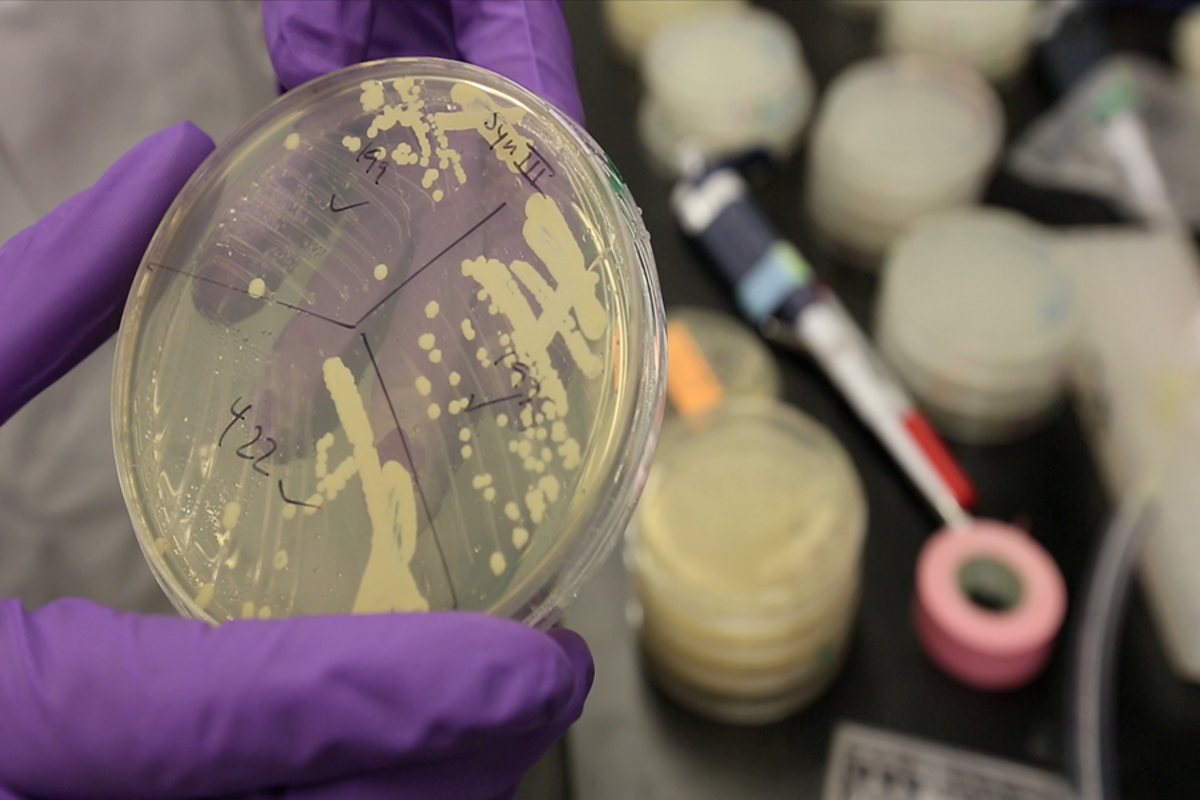

Artificial yeast chromosome brings science one step closer synthetic life
Loading...
Saccharomyces cerevisiae, the humble brewer's yeast cell, just got a designer makeover.
By rebuilding yeast chromosome III (which has 316,617 base pairs), a team of researchers has managed to create the very first synthetic eukaryotic chromosome.
Their findings appear in a paper titled "Total Synthesis of a Functional Designer Eukaryotic Chromosome," published in Science on March 27.
Dubbed synIII, this new chromosome is much smaller, with more than 43,000 fewer base pairs than the chromosome III that nature gave it.
Compared with humans, who have 23 pairs of chromosomes, and bacteria, which has just one chromosome, yeast has 16 chromosomes.
Yeast's chromosome III is "a sentimental favorite" among scientists, Jef Boeke, director of NYU Langone Medical Center's Institute for Systems Genetics and an author of the study, told the Monitor. In addition to being one of the smallest of the 16 chromosomes, it contains information that determines how a cell is going to reproduce, sexually or asexually, he says.
To make the new chromosome tighter, researchers made some 500 alterations to eliminate sections considered repetitive or unnecessary for the cell to grow.
First they got rid of so-called junk DNA, such as repetitive base pairs, and jumping genes, which randomly move around and cause mutations, left by viruses that integrated in the yeast DNA and are causing damage.
Next they inserted DNA sequences called loxPsym sites, to enable "genome scrambling," a process that allow scientists to shuffle genes. On their own, loxPsym sites cannot carry out genome scrambling. For that, the cell needs to have Cre – specifically engineered genes from bacterial viruses.
After the artificial chromosome containing the loxPsym sites is ready, Cre is then introduced, permitting recombination.
"Imagine a deck of cards," said Dr. Boeke in a press release. "We can pull together any group of cards, shuffle the order and make millions and millions of different decks, all in one small tube of yeast. Now that we can shuffle the genomic deck, it will allow us to ask, can we make a deck of cards with a better hand for making yeast survive under any of a multitude of conditions, such as tolerating higher alcohol levels?"
Simply put, the scrambling technique can help scientists construct different kinds of yeast cells, where genes can be arranged to make the cells serve different purposes, from producing biofuels to bread.
But inserting fragments into a chromosome of a single cellular organism requires high level of precision. It took seven years for researchers to achieve this feat.
"When you change the genome you're gambling. One wrong change can kill the cell," said Boeke "We have made over 50,000 changes to the DNA code in the chromosome and our yeast still live."
Changes including the addition or deletion of fragments were first done digitally, using computer-aided design software, before a physical version was ordered, says Joel Bader from John Hopkins University, another author of the paper.
Some 60 undergrads at John Hopkins then came together to make those fragments using chemicals in the laboratory, says Sai Viswanath Narayana Annaluru from the Johns Hopkins Bloomberg School of Public Health, and one of the first authors of the paper.
Computers were also used to control the manufacturing process, which involved giving cues to the students and keeping track of quality-control to ensure there were no errors in the product, Dr. Bader says.
After the artificial cell was ready, it was then "mated" with a normal yeast cell – a technique known as backcrossing – in order to check if the new yeast cell inherited the manipulated chromosome. It did, say researchers.
The bigger aim, though, is to make the remaining 15 chromosomes.
"This work represents the biggest step yet in an international effort to construct the full genome of synthetic yeast," says Boeke.
But there are huge risks associated with synthetic biology, especially what the Presidential Commission for the Study of Bioethical Issues calls an "inadvertent release of a laboratory-created organism into nature and the potential adverse effects of such a release on ecosystems," according to the Presidential Commission for the Study of Bioethical issues.
The paper, says Boeke, has been dedicated to Indian scientists H. Gobind Khorana, who along with Robert W. Holley and Marshall W. Nirenberg jointly won The Nobel Prize in Physiology or Medicine in 1968 for interpreting the genetic code and its function during protein synthesis.
"I wish he was alive to see this," says Boeke.